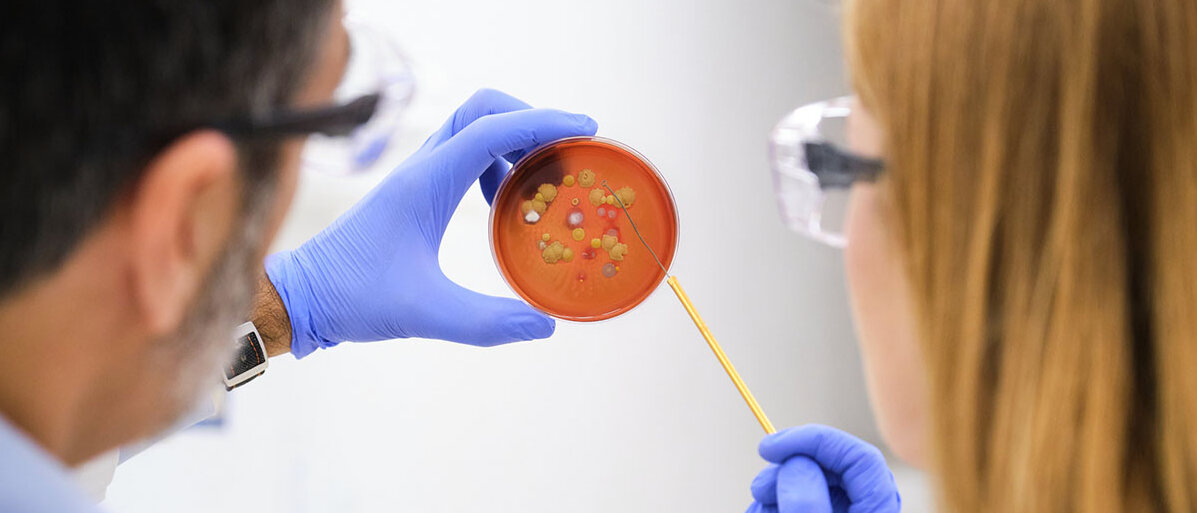

Neuer Ansatz
PATHOBLOCKER: WIE SIE EINE SALMONELLENINFEKTION FRÜHZEITIG STOPPEN
Seite 1/1 2 Minuten
Salmonellen stammen oft aus nicht ausreichend gegartem Fleisch, werden aber auch durch Schmierinfektionen übertragen und sind hochansteckend. Bei einer nachgewiesenen Infektion mit Salmonellen kommen Antibiotika zum Einsatz, aber viele Stämme weisen mittlerweile Resistenzen auf. Der neu entdeckte Pathoblocker geht einen anderen Weg, um die Salmonelleninfektion zu stoppen.
An der Universität Tübingen hat ein Team gezielt nach einem Wirkstoff gesucht, der als Pathoblocker geeignet ist. Salmonelleninfektionen lassen sich mit ihm so früh unterbrechen, dass die Erkrankungen stoppen, bevor sie richtig in Gang kommen.
Pathoblocker kann Salmonelleninfektionen im Beginn stoppen
Die Substanz, die als Pathoblocker gegen Salmonelleninfektionen wirkt und die Erkrankung so stoppen kann, heißt C26. Sie wurde aus Substanzdatenbanken gezielt ausgewählt, weil sie genau in eine Bindungsstelle eines Transkriptionsregulators der Salmonellen passt. C26 verhindert dessen Wirkung. Die Salmonellen können bestimmte Effektorproteine nicht mehr herstellen, die sie zum Eindringen in die Zellen des Magen-Darm-Traktes benötigen. Daher hat das Molekül C26 den Namen Pathoblocker völlig zu Recht: Die Salmonelleninfektion lässt sich mit ihm stoppen, ohne den Keim direkt zu bekämpfen.
Das Team unter der Leitung von Professor Samuel Wagner vom Exzellenzcluster der Universität Tübingen „Kontrolle von Mikroorganismen zur Bekämpfung von Infektionen“ und dem Deutschen Zentrum für Infektionsforschung ist stolz auf seinen Erfolg. In sorgfältiger Arbeit haben die Forschenden Substanzdatenbanken nach Molekülen durchsucht, die in die Bindungstasche des Transkriptionsregulators HiID passen. C26 war der aussichtsreichste Kandidat für eine Wirkung als Pathoblocker. Eine Voraussetzung für Salmonelleninfektionen, die Bildung bestimmter Proteine, lässt sich durch C26 effektiv stoppen.
Der Transkriptionsfaktor verliert durch die Bindung des Pathoblockers seine Wirkung.
Die Salmonellen können daher wichtige Effektorproteine nicht mehr bilden, die sie zum Eindringen in die Zellen der Magen- und Darmschleimhaut brauchen. So ist der Pathoblocker in der Lage, die Salmonelleninfektion frühzeitig zu stoppen.
Verwandte Themen:
Viele Salmonellen besitzen gegen Antibiotika Resistenzen
Der Pathoblocker geht gegen Salmonelleninfektionen nicht nur in der Wirkung neue Wege. Stoppen lässt sich eine Salmonellose zwar meist auch mit Antibiotika, allerdings schaden diese auch den nützlichen Darmbakterien. C26 scheint keinen schädlichen Einfluss auf das Mikrobiom der Behandelten zu haben. Ein weiterer Pluspunkt des Moleküls:
Nach heutigem Kenntnisstand besteht nur eine geringe Wahrscheinlichkeit, dass Salmonellenstämme, wie gegen Antibiotika, Resistenzen gegen den Pathoblocker entwickeln. In Tests kann er Salmonelleninfektionen sehr früh effektiv stoppen.
Wegen seiner spezifischen Wirkung eignet sich C26 in den Augen der Studienautoren gut als Ausgangsstoff für ein Medikament, allerdings ist es bis dahin ein weiter Weg. Ob in Zukunft auf Pathoblocker zurückgegriffen werden kann, um Salmonelleninfektionen in Mensch und Tier zu stoppen, muss sich noch zeigen. Der neue Ansatz könnte aber helfen, auch Salmonellen zu bekämpfen, die gegen Antibiotika Resistenzen entwickelt haben.
Quelle:
https://idw-online.de/de/news850441
https://www.science.org/doi/10.1126/sciadv.adr5235